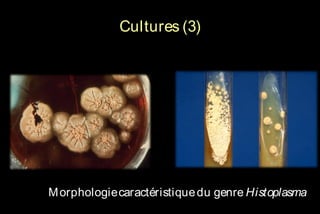
Cultures (3)

M orphologie caractéristique du genre Histoplasma

Le document traite des histoplasmoses, des mycoses profondes causées par les champignons Histoplasma capsulatum et Histoplasma duboisii, avec une augmentation des cas due à l'immunodépression. Il décrit leur épidémiologie, le diagnostic, les symptômes, et les groupes à risque, notamment les immunodéprimés. Enfin, il aborde les méthodes de confirmation et le diagnostic différentiel d'autres pathologies similaires.